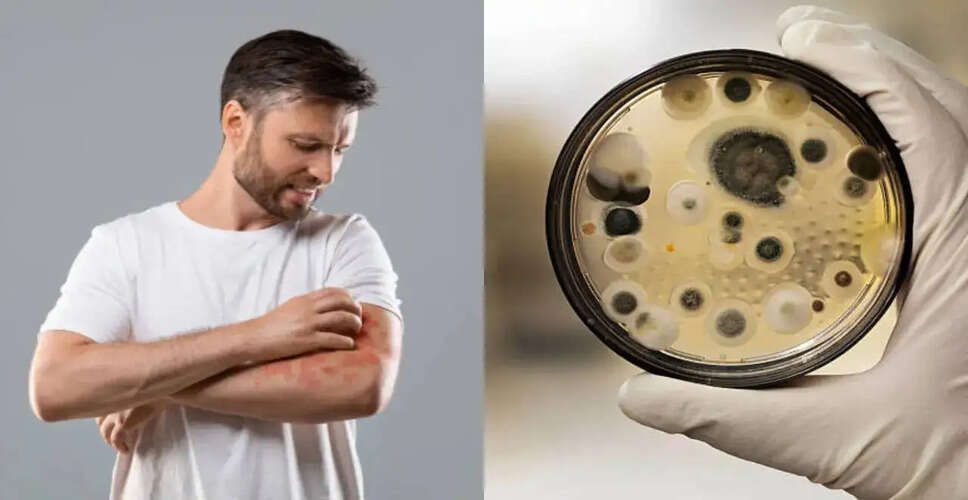
Emerging Threat: The Rise of Drug-Resistant Fungal Infections

Emerging Threat: The Rise of Drug-Resistant Fungal Infections

A Growing Concern in Global Health
The global health sector is raising alarms about a significant and escalating threat: drug-resistant fungal infections. While discussions around pandemics have predominantly focused on bacteria and viruses, experts are now highlighting that certain fungi are developing resistance to existing treatments, which poses a serious and often overlooked risk to public health worldwide. A collective of fifty researchers from various institutions, including the University of Manchester, has issued a warning in the journal Nature Medicine, urging immediate action to prevent fungal infections from becoming untreatable.
The Silent Crisis
Experts estimate that fungal infections impact over a billion individuals globally each year, with millions of severe cases leading to significant mortality rates. The increasing resistance to antifungal medications is making these infections harder to manage. Pathogens such as Candida auris, Aspergillus fumigatus, and Cryptococcus species are evolving resistance to commonly prescribed antifungal drugs, which limits treatment options and raises fatality rates. Unlike bacterial infections, fungal diseases often remain undiagnosed due to a lack of awareness and insufficient diagnostic tools. Symptoms can resemble those of other illnesses, which can delay necessary treatment. In individuals with weakened immune systems, such as cancer patients, transplant recipients, and those with diabetes, these infections can quickly become life-threatening.
Factors Contributing to Drug Resistance
Several factors contribute to the rise of antifungal resistance, including:
- Excessive use of antifungal medications in healthcare and agriculture.
- Climate change, which allows fungi to adapt to higher temperatures and thrive in the human body.
- Widespread use of agricultural fungicides, which accelerates the development of resistance.
- A lack of new antifungal drugs, with innovation lagging behind that of antibiotics.
The 'One Health' approach, which connects human, animal, and environmental health, is increasingly recommended to address this issue comprehensively.
Impact of Climate Change
Rising global temperatures are unexpectedly influencing fungal evolution. Historically, many fungi could not survive at human body temperature. However, as environmental temperatures increase, fungi are adapting, making it easier for them to infect humans. This change significantly expands the pool of potentially harmful fungal pathogens.
Limited Treatment Options
Currently, there are only a few classes of antifungal drugs available. Resistance to even one class can drastically reduce treatment effectiveness. In some instances, infections caused by Candida auris have shown resistance to all major antifungal medications, resulting in 'superbug' fungi that are nearly impossible to treat.
Inadequate Global Preparedness
Despite the escalating threat, fungal infections receive significantly less funding and research attention compared to bacterial and viral diseases. Public health systems worldwide often lack robust surveillance systems for monitoring fungal outbreaks, and diagnostic capabilities are frequently inadequate, especially in low- and middle-income countries. Experts caution that without immediate action, drug-resistant fungi could lead to outbreaks with pandemic-like repercussions, particularly in hospital environments where vulnerable patients are concentrated.
Experts are calling on governments and international organizations to prioritize antifungal resistance before more infections become untreatable. Professor Mike Bromley from the University of Manchester stated, 'Farmers use large quantities of fungicides to protect crops, and some of these chemicals persist in the environment for decades. There is now clear evidence that these chemicals are aiding fungi in evolving into strains that can no longer be treated in humans, plants, or animals.' He added, 'If we don’t act, we will see more infections that simply can’t be cured, which jeopardizes lives and food supplies.'
Strategies to Combat Fungal Infections
Health experts propose a five-step global strategy to address this issue:
- Enhance surveillance systems for early detection.
- Invest in research and development of new antifungal drugs.
- Regulate the use of agricultural fungicides.
- Improve diagnostic and healthcare infrastructure.
- Raise awareness among healthcare professionals and the public.
Drug-resistant fungi pose a looming global health crisis that requires urgent attention. While not yet at pandemic levels, the current trajectory is alarming.
